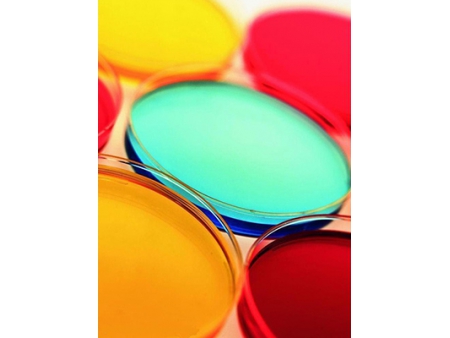

Aplicación de molienda de tintas, pigmentos y colorantes
Soluciones de producción de tinta de impresión de alta calidad
La tinta es un tipo de material de impresión compuesto de diversos materiales dispersos de manera uniforme como el caso de pigmentos, tintes, resinas, solventes, lubricantes, surfactantes, fluorescentes, entre otros. Este tipo de tinta se puede encontrar en aplicaciones como la impresión de libros, ropa, materiales de envasado, placas de circuito electrónico, entre otros. Está más decir que la calidad de la impresión se basa en el tamaño de la partícula de la tinta, por lo que cuan más fina sea, el efecto de impresión será más clara y suave inclusive con menos consumo de tinta. Es por esta razón que las tintas deben ser trituradas una o más veces para poder obtener un menor tamaño de la partícula previo a su uso.
En la parte inferior puede apreciar los resultado de la molienda ultra fina de tintas a chorro o inyección gracias a nuestros molinos de inmersión. En el caso de ser la partícula de tamaño gruesa y amplia en distribución presentará mayor irregularidad y aspereza en la partícula. Posterior al proceso ultra fino de la molienda las partículas alcanzarán tamaño nanométricos y presentaran una gran esfericidad, gran distribución y diseminación, lo que ante todo garantiza una gran calidad en la tinta. Nuestros molinos de inmersión han ocupado un rol importantes en líneas de producción de empresas en diversas partes del mundo, brindando grandes beneficios económicos por la calidad generada.
- Antes de la molienda

- Después de la molienda
| Tamaño caracterizado | Alimentación | Productos |
| D50(μm) | 18.00 | 0.04 |
| D90(μm) | 31.00 | 0.05 |

- Distribución del tamaño de las partículas de tinta de lentes de contacto (verde)

- Distribución del tamaño de las partículas de tinta de lentes de contacto (azul)
| Muestras | D25(μm) | D50(μm) | D75(μm) | D90(μm) |
| Tinta verde | 0.021 | 0.023 | 0.025 | 0.034 |
| Tinta azul | 0.025 | 0.028 | 0.031 | 0.040 |